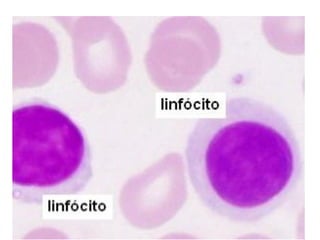

1. O documento descreve os principais aspectos da resposta imune adaptativa, incluindo a estrutura e função dos anticorpos, as bases celulares da formação de anticorpos, e a memória imunológica.
2. A resposta imune adaptativa existe para combater microrganismos que escapam da resposta imune inata. Ela envolve linfócitos B e T que reconhecem antígenos de forma específica.
3. A resposta imune pode ser ativa, induzida pela exposição a um antígeno, ou passiva, confer

![Referências
MARTINEZ, Alfredo Córdova & ALVAREZ-MON, Melchor. O sistema
imunológico (II): importância dos imunomoduladores na recuperação do
desportista. Rev Bras Med Esporte [online]. 1999, vol.5, n.4, pp.159-166.
ISSN 1517-8692.
ABBAS, A. K., Lichtman, A. H. Imunologia Celular e Molecular, 5º ed. Rio
de Janeiro: Elsevier, 2005.
BRASILEIRO FILHO, G. Bogliolo - Patologia. 8. ed. Rio de Janeiro: Gen,
Guanabara Koogan, 2011.
CALICH, V.; VAZ, C. Imunologia. Rio de Janeiro: Revinter, 2001.](https://image.slidesharecdn.com/aula3-imunidadeadaptativa-180828203755/85/Imunidade-adaptativa-36-320.jpg)